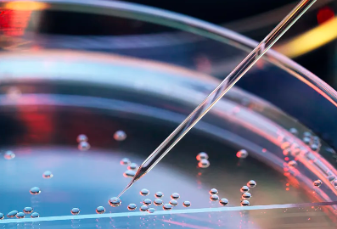
image.png

干細(xì)胞抗衰老有哪些顯著功效?如何評估其效果與安全?
2024-11-01 14:13:32 來源: 小編 咨詢醫(yī)生
干細(xì)胞抗衰老技術(shù)近年來在生物醫(yī)學(xué)領(lǐng)域備受矚目,其顯著的抗衰老功效和潛力吸引了眾多科研人員和消費者的關(guān)注。本文將從干細(xì)胞抗衰老的顯著功效、效果評估以及安全性等方面進(jìn)行深入探討,以期為讀者提供有價值的信息。
一、干細(xì)胞抗衰老的顯著功效
1.促進(jìn)細(xì)胞再生與修復(fù):干細(xì)胞具有強(qiáng)大的自我更新和分化能力,可以分化為多種類型的細(xì)胞,從而替代衰老、受損的細(xì)胞,恢復(fù)組織器官的正常功能。
2.改善皮膚狀況:干細(xì)胞可以分化為皮膚細(xì)胞,促進(jìn)皮膚細(xì)胞再生,改善皮膚彈性、減少皺紋,使肌膚煥發(fā)青春光彩。
3.增強(qiáng)免疫力:干細(xì)胞具有免疫調(diào)節(jié)作用,可以增強(qiáng)機(jī)體免疫力,預(yù)防疾病。
4.改善神經(jīng)系統(tǒng)功能:干細(xì)胞可以分化為神經(jīng)元,修復(fù)受損的神經(jīng)系統(tǒng),改善記憶力、反應(yīng)速度等。
5.抗氧化作用:干細(xì)胞可以清除體內(nèi)的自由基,降低氧化應(yīng)激,減緩衰老過程。
二、如何評估干細(xì)胞抗衰老的效果與安全?
1.效果評估:
(1)生理指標(biāo):通過檢測血液、尿液等生理指標(biāo),評估干細(xì)胞抗衰老的效果。如:血常規(guī)、肝功能、腎功能、免疫指標(biāo)等。
(2)皮膚指標(biāo):觀察皮膚彈性、皺紋、色斑等變化,評估干細(xì)胞抗衰老對皮膚改善的效果。
(3)神經(jīng)系統(tǒng)指標(biāo):通過神經(jīng)心理測試,評估干細(xì)胞抗衰老對神經(jīng)系統(tǒng)功能的改善作用。
2.安全性評估:
(1)細(xì)胞質(zhì)量:對干細(xì)胞進(jìn)行嚴(yán)格的生物學(xué)檢測,確保其安全、純凈。
(2)毒理學(xué)研究:對干細(xì)胞及其制品進(jìn)行毒理學(xué)研究,評估其毒副作用。
(3)臨床觀察:在臨床試驗中,觀察受試者使用干細(xì)胞抗衰老制品后的不良反應(yīng),評估其安全性。
三、總結(jié)
干細(xì)胞抗衰老技術(shù)具有顯著的抗衰老功效,可以為人們帶來健康、年輕的生活。然而,評估其效果與安全仍需進(jìn)一步研究。在選擇干細(xì)胞抗衰老產(chǎn)品時,消費者應(yīng)關(guān)注產(chǎn)品的質(zhì)量、安全性以及臨床驗證,以確保自身的健康與安全。隨著科研技術(shù)的不斷發(fā)展,相信干細(xì)胞抗衰老技術(shù)將為更多人帶來福祉。
- 2024-09-02干細(xì)胞抗衰老應(yīng)用有哪些,應(yīng)用原理是什么
- 2024-11-18干細(xì)胞抗衰老的中成藥有哪些,效果如何
- 2024-10-11干細(xì)胞抗衰老的費用是多少?性價比如何?
- 2024-11-06臍帶干細(xì)胞抗衰老效果如何?
- 2024-11-18干細(xì)胞面部抗衰安不安全,有沒有效果
- 2024-12-09未來干細(xì)胞會用來抗衰老嗎,干細(xì)胞未來發(fā)展前景
- 2024-09-27廣州貝拉國際醫(yī)療中心怎么樣
- 2024-09-07干細(xì)胞研究的前景怎么樣,干細(xì)胞治療的前景和現(xiàn)狀
- 2024-09-02上游干細(xì)胞存儲中游機(jī)構(gòu),細(xì)胞存儲公司排名前十
- 2024-09-14干細(xì)胞療法軟骨哪些醫(yī)院可以做
- 2024-08-06干細(xì)胞醫(yī)療技術(shù),干細(xì)胞醫(yī)療技術(shù)發(fā)展前景
- 2024-07-29脂肪干細(xì)胞抗衰,脂肪干細(xì)胞抗衰效果好嗎
- 2024-09-20糖尿病干細(xì)胞治療多少錢,哪個醫(yī)院好
- 2024-09-02上游干細(xì)胞存儲中游機(jī)構(gòu),細(xì)胞存儲公司排名前十
- 2024-08-04新生兒干細(xì)胞儲存費用,新生兒干細(xì)胞儲存有必要嗎
- 2024-10-07干細(xì)胞儲存合法機(jī)構(gòu)有哪些,如何選擇可靠的存儲服務(wù)
- 2024-08-30美國干細(xì)胞治療帕金森,干細(xì)胞治療PD最新消息
- 2024-09-09江西免疫干細(xì)胞功效,回輸有風(fēng)險嗎
